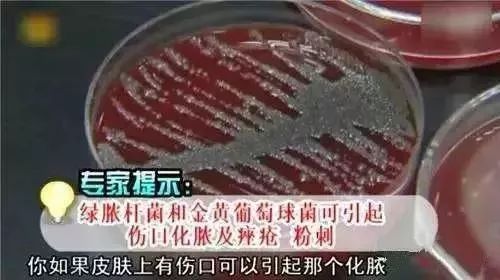
用什么洗毛巾最干净又没有螨虫,怎么去除毛巾的螨虫和细菌

小珠子发现:一般人买毛巾都会用很长一段时间,除非破了洞,否则不会轻意扔掉。
可是,你知道这样的毛巾有多脏吗?

普通毛巾采用纯棉面料,不透气,不易干,非常容易发黄发黑,滋生螨虫。

实验测试,3个月不换的毛巾里面的螨虫达600万只。感觉每擦一次,就有上百万只螨虫在脸上游走。

长时间接触,皮肤会无缘无故瘙痒,脸上痘痘莫名其妙变多,毛孔越来越粗大。

这是因为一般的毛巾都是纤维绞缠结构,容易沾染皮肤残留物,清洗不到位,这就会滋生大肠杆菌等致病菌。
如果脸上刚好有伤口,接触后容易引起感染发炎,甚至化脓肿胀。
面对这种困扰,日本专家把毛巾设计成蜂窝状,能有效抵御92%的螨虫、细菌。

蜂窝设计,抗菌性强
市面上的很多抗菌毛巾都会在里面添加化学抗菌剂。
经常接触抗菌剂,不仅有害健康,还容易使细菌产生抗体,达不到原有抗菌效果。

蜂窝毛巾用的是最天然的物理抗菌法。
毛巾使用日本进口的织机,采用最新的中空网纱制造工艺,以蜂巢组织结构布局。

3600个蜂窝设计,利于水分流动。水流一冲,轻松把附着的灰尘、皮屑洗掉,破坏细菌生长环境。
4mm大洞孔更易于水分蒸发,快速形成干燥环境,长效抑菌。

面料轻盈,轻轻松松就能拧干水
精选日照时间长达18个小时的*疆新**长绒棉。棉花细腻雪白,纤维长度达37毫米,符合国家特级标准。
超高蓬松度,被誉为棉中贵族。

每一朵棉花都需要经过15道工序的严格筛选,制作一条毛巾约耗费110朵棉花。
摸上去松松软软,非常轻盈,扑在上面,舒适到像跌进了恋人的怀抱。

蓬松的面料使其重量比普通毛巾轻1/3,很好拧,女生轻松就可以拧干。
3秒吸水,能力超强
三针五线式缝边,线圈规律整齐,洞孔与洞孔间的平均距离为2mm,可以更好地吸收传导水分。

放在水里,3秒瞬间吸收,可以与被称为“棉中黄金”的埃及棉pk。

完全不掉色,更安心
一些黑心工厂用富含芳香胺类等致癌物质染料染制毛巾。使用后会使皮肤过敏,损害健康。


蜂窝毛巾采用纯天然植物染料,整匹染色,这是来自大自然最真实的面相。

不添加任何化学物质,放在水里浸泡一天都不掉色,用起来更安心。
每一条毛巾都经过权威机构检测,达到真正的无毒环保。

现在某宝上的蜂窝毛巾动辄卖到60~80元/条。

同样的品质,为了回馈老顾客,珠江驾到现在只需两条38元,前2000名,买四条还送多一条哦。

一条作为擦脸的毛巾,一条作为包裹身体的浴巾。柔软亲肤,才是对身体的最大呵护。
晚上回家,卸下白天的坚强,用蜂窝毛巾西区疲惫,从这一刻开始享受:享受毛巾给肌肤带来的轻柔触感,享受温馨、舒适与安全。
珠江驾到粉丝福利
「 蜂窝纯棉毛巾浴巾两件套 」
一条能抗菌的毛巾,3秒瞬吸享受沐浴
¥ 38/毛巾x2(体验装)
¥ 69/毛巾+浴巾(沐浴装)
¥ 76/毛巾x5(家庭装)
扫描二维码立即抢购

戳阅读原文,直达
珠江驾到!